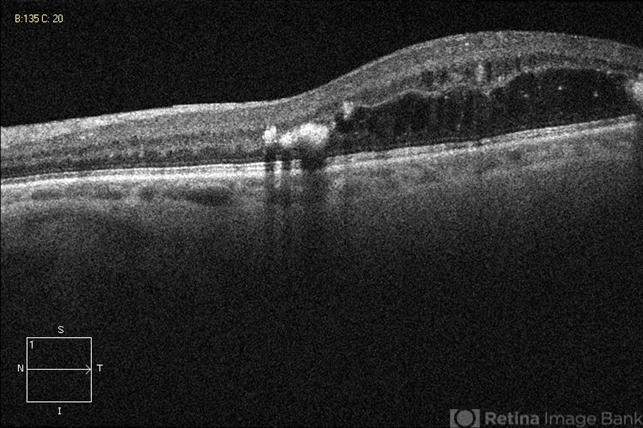
file

-
 By John S. King, MD
By John S. King, MD
Retina Associates, PA - Uploaded on Aug 24, 2012.
- Last modified by Jennifer Hicks on Sep 5, 2012.
- Rating
- Appears in
- Miscellaneous
- Condition/keywords
- circinate ring
- Photographer
- Kristin Konecki, OcuSight Eye Care Center, Rochester, NY
- Imaging device
- Optical coherence tomography system
- Description
- DR; hard exudate at edges of macular edema and are hyper-reflective with shadowing.

Initializing download.
Initializing download.










